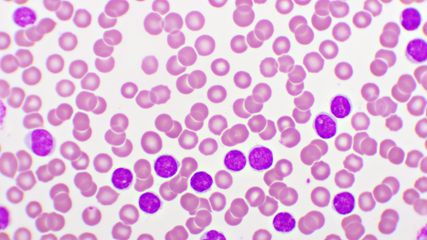

Verlängertes OS mit NALIRIFOX in der ersten Therapielinie
Bericht: Dr. Ine Schmale
Sie sind bereits registriert?
Loggen Sie sich mit Ihrem Universimed-Benutzerkonto ein:
Sie sind noch nicht registriert?
Registrieren Sie sich jetzt kostenlos auf universimed.com und erhalten Sie Zugang zu allen Artikeln, bewerten Sie Inhalte und speichern Sie interessante Beiträge in Ihrem persönlichen Bereich
zum späteren Lesen. Ihre Registrierung ist für alle Unversimed-Portale gültig. (inkl. allgemeineplus.at & med-Diplom.at)
Mit den Ergebnissen der NAPOLI-3-Studie für das Gesamtüberleben (OS) und progressionsfreie Überleben (PFS) wurde ein signifikanter und klinisch relevanter Vorteil durch eine Erstlinientherapie mit NALIRIFOX gegenüber Gemcitabin plus nab-Paclitaxel bei Patient*innen mit metastasiertem Pankreaskarzinom gezeigt. Diese Ergebnisse wurden beim ASCO vertieft.
In der NAPOLI-3-Studie erhielten insgesamt 770 Patient*innen mit bestätigtem Adenokarzinom des Pankreas, die bisher keine Behandlung für die metastasierte Erkrankung erhalten hatten, randomisiert das NALIRIFOX-Regime (liposomales Irinotecan, 5-FU/LV, Oxaliplatin) oder Gemcitabin plus nab-Paclitaxel. Als primärer Endpunkt wurde das OS untersucht.
Mit einer medianen Nachbeobachtungszeit von 16,1 Monaten hatten 85,1 % der Patient*innen im NALIRIFOX-Arm versus 96,1 % im Kontrollarm die Therapie abgebrochen, in beiden Studienarmen hauptsächlich aufgrund einer fortschreitenden Erkrankung. 14,1 % der Patient*innen hatten NALIRIFOX aufgrund von Nebenwirkungen abgebrochen sowie 23,8 % Gemcitabin plus nab-Paclitaxel.
Im Median lebten die Patient*innen der ITT-Population 11,1 versus 9,2 Monate (HR = 0,83; 95% CI: 0,70–0,99; p = 0,04). Nach 12 Monaten waren 45,6 % versus 39,5 %, nach 18 Monaten 26,2 % versus 19,3 % der Patient*innen noch am Leben. Ein Vorteil für das NALIRIFOX-Regime wurde für alle untersuchten Subgruppen bestätigt. Für das PFS wurde ein Median von 7,4 Monaten versus 5,6 Monate beobachtet (HR = 0,69; 95% CI: 0,58–0,83; 0 < 0,0001). Nach 12 Monaten lebten 27,4 % versus 13,9 % und nach 18 Monaten 11,4 % versus 3,6 % der Patient*innen ohne Progress. Auch für das PFS konnte der Vorteil in allen untersuchten Subgruppen beobachtet werden. Die Ansprechrate betrug 41,8 % versus 36,2 %, mit einer medianen Dauer der Remissionen von 7,3 Monaten versus 5,0 Monate.
Mit einer medianen Dauer der Studienmedikation von 24,3 versus 17,6 Wochen wurden vergleichbar häufig Nebenwirkungen Grad ≥ 3 (87,0 % vs. 86,0 %), therapieassoziierte Nebenwirkungen Grad ≥ 3 (70,8 % vs. 68,1 %) und klinisch relevante Nebenwirkungen (54,3 % vs. 51,5 %) berichtet. Es wurden keine neuen Sicherheitssignale beobachtet.
Damit sei NALIRIFOX ein neues Referenzregime für die Erstlinienbehandlung von Patient*innen mit metastasiertem Adenokarzinom des Pankreas, schlossen die Autoren.
Quelle
O'Reilly EM et al.: Liposomal irinotecan + 5-fluorouracil/leucovorin + oxaliplatin (NALIRIFOX) versus nab-paclitaxel + gemcitabine in treatment-naive patients with metastatic pancreatic ductal adenocarcinoma (mPDAC): 12- and 18-month survival rates from the phase 3 NAPOLI 3 trial. ASCO 2023, Abstr. #4006
Das könnte Sie auch interessieren:
ASCO Newsroom 2023
Hier finden Sie die wichtigsten neuen Daten vom Jahreskongress der American Society of Clinical Oncology. In kurzen Videostatements präsentieren namhaften Expert*innen ihre Highlights.
Effektive und sichere Therapie für ältere Patient*innen
Alliance A041703: Kombination von Inotuzumab Ozogamicin (InO) als Induktions- und Blinatumomab als Konsolidierungstherapie verlängert ereignisfreies Überleben
Pembrolizumab verlängert OS und PFS in Kombination mit Chemotherapie
Neue Therapieoption als Ergänzung zu Platin-haltiger Chemotherapie mit Pemetrexed (CP)